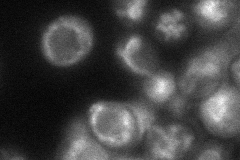
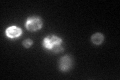

View description
Vacuolar Ca2+ ATPase involved in depleting cytosol of Ca2+ ions; prevents growth inhibition by activation of calcineurin in the presence of elevated concentrations of calcium; similar to mammalian PMCA1a
Localization:
Intensity:
Fold change:
Significance:
-
C’ GFP library in SD

vacuole membrane24.13 -
N' NOP1pr-GFP in SD

vacuole membrane114.1 -
N' TEF2pr-mCherry in SD

vacuole membrane133.469 -
N' NATIVEpr-GFP in SD

vacuole membrane27.4508 -
N' TEF2pr-VC and Cyto-VN in SD
vacuole membrane50.6747 -
C’ GFP library in SD+DTT

vacuole membrane37.091.53Yes -
C’ GFP library in SD+H2O2

vacuole membrane26.161.08No -
C’ GFP library in Starvation Media
vacuole membrane113.384.69Yes -
C’ GFP library on the background of Pup2-DaMP

vacuole membrane -
C’ GFP library on the background of CCT mutant

vacuole membrane19.31650.800286No
